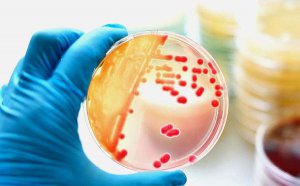
<b>����������ʲô��˼_�¹ڲ�������������ôԤ����</b>

知识问答
-

什么是环境传人_环境传人有哪些危害?
相信大家都看过了新冠病毒出现环境传人的新闻,为了帮助大家了解更多关于环境传人的概念、环境传人的危害、环境传人的预防等内容,特整理本文,希望大家不要麻痹大意、一定要做好个人防护。 什么是环境传人? 钟南山在公开场合提出,新冠病毒出现环境传人...
2022-03-24 -

环境传人是什么意思_和人传人有什么区别?
环境传人虽然只有短短的四个字,却关乎着亿万人的生命安全,对于环境传人的概念,相信绝大多数人都是一头雾水,那么环境传人是什么意思?环境传人怎么预防?环境传人和人传人有什么区别,下面就来了解一下。 环境传人是什么意思? 环境传人,是病毒传播途...
2022-03-24 -
环境传人是什么意思_新冠病毒环境传人怎么预防?
12月19日,共和国勋章获得者、中国工程院院士、国家呼吸系统疾病临床医学研究中心主任钟南山表示,新冠病毒原来是人传人,现在出现了一个新的课题:环境传人。那么环境传人是什么意思?新冠病毒出现环境传人怎么预防?各地新冠疫苗接种方案是什么?下面就...
2022-03-24 -

天不言而四时行地,不语而百物生.是什么意思?
天不言而四时行,地不语而百物生。这句话是什么意思?天不言而四时行,地不语而百物生。的出处是哪里?下面为大家整理了天不言而四时行,地不语而百物生。的详细解释,希望可以帮助到大家。 天不言而四时行地不语而百物生是什么意思? 意思是:天不会说话...
2022-03-24 -

天不言而四时行,地不语而百物生是什么意思_出处是哪里?
在人与自然和谐相处的过程中,我们从中也获取了很多的灵感与智慧,其中天不言而四时行,地不语而百物生。这句话就是代表,那么,天不言而四时行,地不语而百物生。是什么意思,是谁说的,出自哪里呢, 天不言而四时行,地不语而百物生。 出处是哪里呢?下...
2022-03-24 -

月宫之吻是什么意思_月宫之吻是如何完成的(动图)
月宫之吻是什么意思?此次,月宫之吻指的是携带着月壤的嫦娥五号上升器与在环月轨道上的轨道器、返回器组合体成功实现交会对接,下面就带大家来了解一下月宫之吻是如何完成的? 月宫之吻是什么意思? 北京时间2020年12月6日凌晨,携带着月壤的嫦娥五号上升...
2022-03-24 -

割韭菜是什么意思_股市的割韭菜是怎么回事?
割韭菜以此不知道从什么时候和股市扯上了关系,也不知道这个梗是谁发明的,当初看似两个毫无关系的词,如今看起来竟然如此搭配,那么,割韭菜是什么意思?在股市上被割韭菜是怎么回事呢?如何防止被割韭菜呢?下面就来详细了解一下。 什么叫割韭菜? 割韭...
2022-03-24 -

“不惰者,众善之师也”是什么意思_出自哪里?
日常生活中,我们会接触到各种励志语句,其中不惰者,众善之师也。这句话很受欢迎,在我们学习劳模精神、工匠精神的时候也会接触到这句话,那么,不惰者,众善之师也是什么意思,是谁说的,出自哪里呢,不惰者,众善之师也的前一句是什么,下面就来详细了...
2022-03-24 -

躺平是什么意思_为什么越来越多的年轻人选择躺平?
最近,在年轻人中流行一种说法:只要你选择躺平,世界就会为你让路。有人分享了自己的躺平心得,有人出了躺平攻略,那么,躺平是什么意思?为什么越来越多的年轻人选择躺平?躺平又有哪些弊端?下面就来详细了解一下躺平这个词的具体解释和由来,以及各方...
2022-03-24 -

郁金香的花语是什么_郁金香花语大全
郁金香有着高雅神秘,给人以清新脱俗的感觉,每当看到含苞欲放的郁金香,心中总是泛起蠢蠢欲动的爱意,在16世纪, 郁金香被称为世界花后也是土耳其、匈牙利、荷兰、伊朗的国花 ,你知道郁金香的花语是什么吗?让我们一起了解一下吧! 一、郁金香简介 (1)...
2022-03-24 -

“青山一道同云雨,明月何曾是两乡”是什么意思_出处是哪里?
日本舞鹤市政府驰援大连的物资,每一个纸箱上都书写着青山一道同云雨,明月何曾是两乡。那么,青山一道同云雨,明月何曾是两乡是什么意思?出处是哪里?为什么要写上这两句话呢?下面就来了解一下。 事件回顾 据介绍,自新冠肺炎疫情发生以来,国际友好城...
2022-03-24 -

被PUA是什么意思_pua男是什么意思网络语?
最近,PUA这个话题再一次成为了热点,原因是有女大学生反映遇到了pua男,自己被PUA了,那么,被PUA是什么意思,女大学生口中的pua男是什么意思呢?下面就来了解一下什么是PUA. PUA是什么意思? PUA的全称是Pick Up Artist,从字面上看就是搭讪艺术学的意思...
2022-03-24 -

只争朝夕不负韶华是什么意思_只争朝夕不负韶华的含义
大家对只争朝夕,不负韶华并不陌生,只争朝夕的意思很好理解,但是不负韶华就有人不知道是什么意思了,尤其是韶华的含义更让人很难懂,下面就为大家带来只争朝夕不不负韶华的详细解释及读音,希望帮助大家理解只争朝夕,不符韶华是什么意思。 只争朝夕不负...
2022-03-24 -

鬼影是什么_是“鬼影”还是“轨影”?
6月17日15时54分,神舟十二号与天和核心舱完成交会对接。作为此次交会对接的指令长,聂海胜在反复确认:请问一下是不是有鬼影?那么,鬼影是什么?是鬼影还是轨影?如果是轨影,那么,什么是轨影呢?下面就来为大家揭秘。 聂海胜:哪个鬼影是真的? 6月17日...
2022-03-24 -

莎气腾腾是什么意思_莎气腾腾的详细解释
最近几天,网络新词莎气腾腾被大家熟知,那么,莎气腾腾是什么意思?该怎么解释莎气腾腾这个词语呢,下面就为大家带来莎气腾腾的详细解释以及杀气腾腾的由来。 莎气腾腾是什么意思? 莎气腾腾改自成语杀气腾腾,特指2021年7月29日上午,东京奥运会乒乓球女...
2022-03-24 -

什么是元宇宙_元宇宙是什么意思_为什么元宇宙火了?
前一段时间,突然被元宇宙这个比较抽象的概念刷屏了,宇宙的概念大家都比较了解,但是,元宇宙是什么意思?该如何定义元宇宙?下面就为大家详细介绍一下, 什么是元宇宙?为什么元宇宙火了? 希望通过本文能够帮助大家更加深刻的了解元宇宙这个词。 什么是...
2022-03-24 -

为什么Facebook将公司名改为Meta_Meta是什么意思?
当地时间10月28日,Facebook首席执行官马克扎克伯格在Facebook Connect大会上宣布,Facebook将更名为Meta,作为互联网巨头,为什么Facebook将公司名改为Meta,具体是什么原因呢?改了Meta后有什么好处?原来的Facebook怎么处理,下面就来详细了解一下。 为...
2022-03-24 -

什么是时空伴随者_时空伴随人员什么意思?
最近,在疫情防控的关键时期,很多人接到了关于时空伴随风险的提示,因此也出现了一个新的名词叫时空伴随者。那么,什么是时空伴随者?时空伴随人员是什么意思?如果,自己变成了时空伴随者该怎么办呢?下面就详细为大家介绍一下时空伴随者这个词的由来,...
2022-03-24 -

EDG战队是什么意思_edg是哪个国家的战队?
2021年11月6日,在英雄联盟S11总决赛中,中国LPL赛区战队EDG电子竞技俱乐部获得2021年英雄联盟全球总决赛冠军!于是很多人想弄清楚EDG战队是什么意思,edg是哪个国家的战队?下面就详细为大家介绍一下。 EDG战队是什意思? EDG是英语EDward Gaming的简称,...
2022-03-24 -

乾隆白菜是凉菜吗_为什么叫乾隆白菜?
最近,大家都知道了乾隆白菜,乾隆白菜有什么神奇的地方吗?今天和大家探讨一下乾隆白菜是不是凉菜,包括乾隆白菜名字的由来、乾隆白菜的做法,下面跟着小编的节奏一起来了解这个制作简单、名字大气的乾隆白菜。 乾隆白菜是凉菜吗? 根据百度百科给的信息...
2022-03-24

